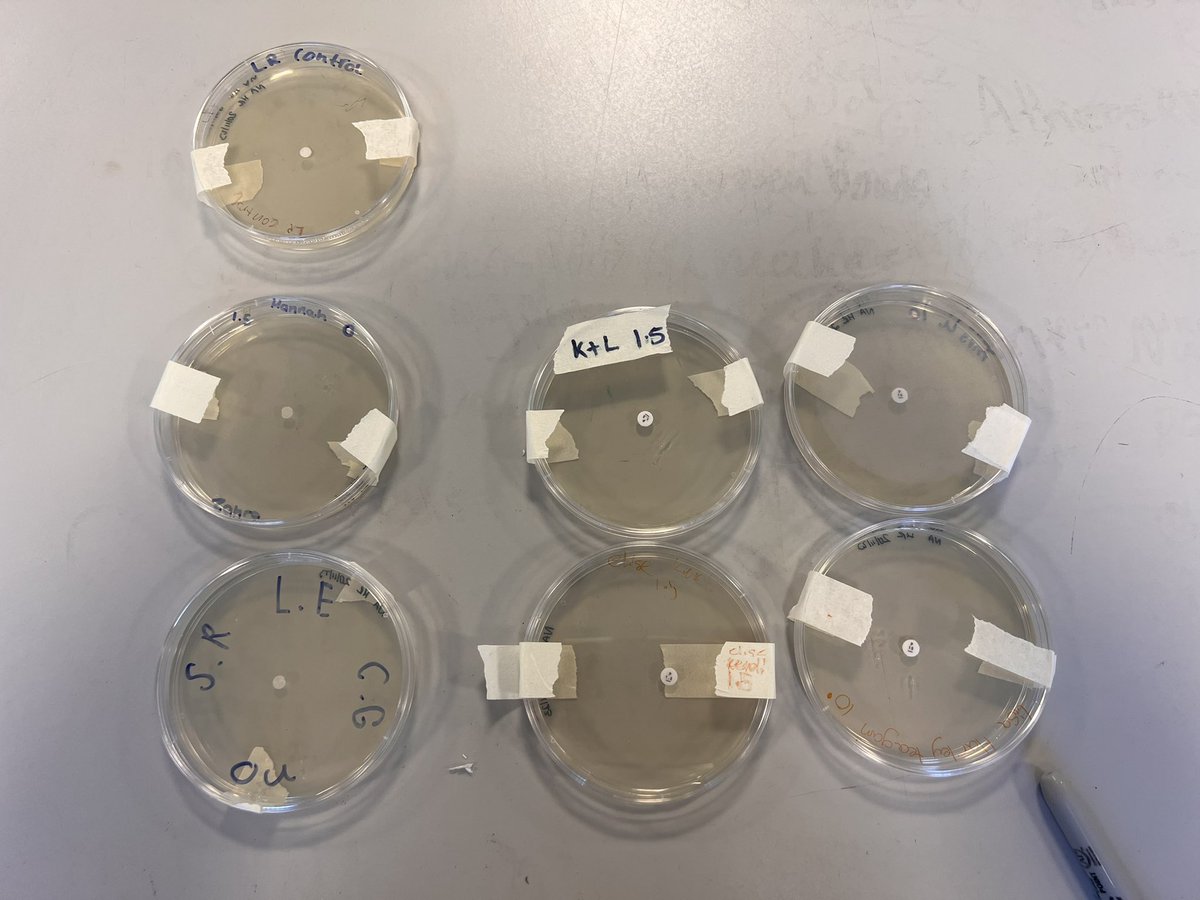
MintlawSci's tweet image. S3 Biology have been learning about antibiotics and the use of them for bacterial infections. Here are the before and after pics of their plates. Of course, we needed to learn about Sir Alexander Fleming along the way too!🏴󠁧󠁢󠁳󠁣󠁴󠁿 #LearningTogether #AsepticTechnique
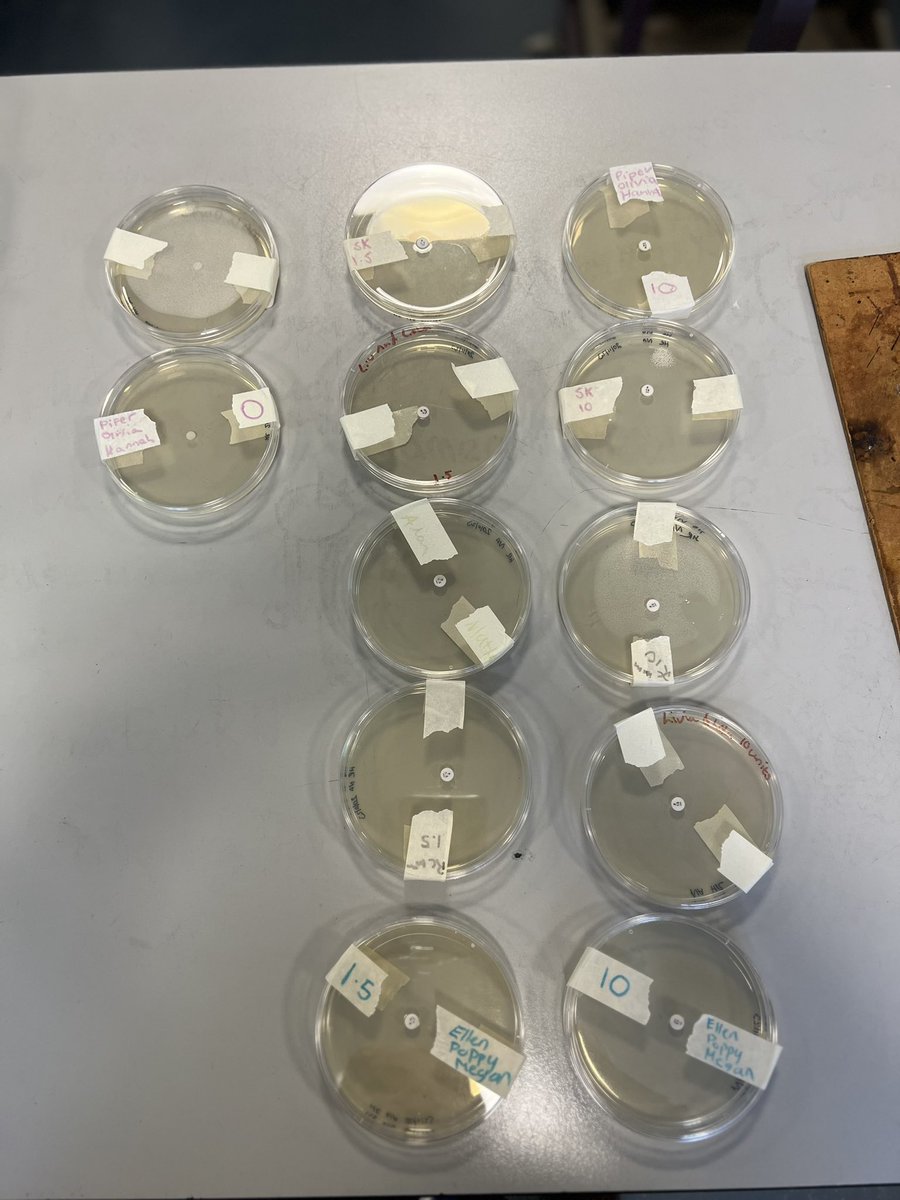
MintlawSci's tweet image. S3 Biology have been learning about antibiotics and the use of them for bacterial infections. Here are the before and after pics of their plates. Of course, we needed to learn about Sir Alexander Fleming along the way too!🏴󠁧󠁢󠁳󠁣󠁴󠁿 #LearningTogether #AsepticTechnique

#aseptictechnique 搜索结果
Having a brilliant day facilitating wound care #simulation with our amazing September 2022 adult nursing students!! @ShuAdultNursing @sheffhallamuni #learningisfun #aseptictechnique #notouchtechnique

Thank you @Corning @VWR for an in-person #laboratory demonstration on #tissueculture and #aseptictechnique for new lab members. @WeillCornell #CancerResearch



Alam kong mahirap sa simula pero kailangan mo kumawala kung nasan kaman. Matuto sa mga pagkakamali, buksan ang pag-iisip, at mag-mahal muli sa tamang oras at panahon. ❤️ #sidedrip #startnewline #aseptictechnique #nursehokage

S3 Biology have been learning about antibiotics and the use of them for bacterial infections. Here are the before and after pics of their plates. Of course, we needed to learn about Sir Alexander Fleming along the way too!🏴 #LearningTogether #AsepticTechnique




Great poster by @ValWeston6 @fionahammond74 on achieving informal #consensus on #aseptictechnique for shared #learning and understanding @teamCNO_ @Lisaritchie111 @samalexmatthews #IP2023Conf

Great 1st session of our Sterile Compounding & Aseptic Technique Training! Participants loved it & are eager to learn more. #pharmacytraining #sterilecompounding #aseptictechnique




Test your knowledge! What is the definition of aseptic technique?? A) B) C) D) Vote & share your best #aseptictechnique tip in the replies! #infectionprevention #patientcare

Aseptic technique is vital in nursing, with varied applications. This review of 2812 studies and 31 articles reveals differences in terminology around aseptic technique. This will guide future research #Nursing #AsepticTechnique #Research journalofhospitalinfection.com/article/S0195-…
journalofhospitalinfection.com
Aseptic technique in clinical nursing settings: a scoping review
Aseptic technique forms a component of standard precautions and is a foundational concept in nursing practice. The application of that standard appears to vary between context and nurse. The variat...
One week later from the index case (my 7 year old), I am the last one standing from the 6 in our home. I am not going down with norovirus (stomach flu) without a fight. Armed with bleach and lots of hand washing! #VirologyProf #FightingHard #AsepticTechnique

IV compounding challenge: Can you spot the TINY mistake that could lead to a BIG problem? Drop your answer in the comments & see if you're a sterile compounding master!🥼 #qualifiedhub #sterilecompounding #aseptictechnique #pharmacy

The wait is almost over! Get ready to be inspired! Stay tuned! News and testimonials are coming soon. #sterilecompounding #aseptictechnique #pharmacy #training #successstories #nextround #qualified_hub #qualified_pharmacists_hub #pharmacist

What do you think presents the biggest challenge in implementing the recommended sterile compounding techniques and guidelines? Leave a comment below with your guess! #sterilecompounding #aseptictechnique #pharmacy

Do you know of a major infection outbreak that played a role in the development of sterile compounding practices? Share your knowledge or best guesses in the comments below! #qualifiedhub #sterilecompounding #aseptictechnique #pharmacy

Doctors, can you ace this sterile compounding quiz? Show off your aseptic technique knowledge! Take it now & see if you're an expert! #sterilecompounding #aseptictechnique #MayTraining

#AsepticTechnique 🦠 🧼 ✋ 🤚 #mroshieldsscience #Science #WashYourHands #LabSkills #AvoidContamination #chemistry #mroshieldschemistry #handwashing
Want to stay ahead of the curve and gain in-depth knowledge? Enroll now qualified.ws/sterile-compou… #sterilecompounding #aseptictechnique #pharmacy #training #qa #healthcare #qualitips #qualified_hub #qualified_pharmacists_hub #ChemoMyths #pharmacist #SterileCompounding

🧑⚕️💊 Aseptic Gowning in Action! Pharmacy technician students are mastering aseptic technique, ensuring contamination-free medication prep. From gloves to gowns, every step matters for patient safety! 🏥✨ #pharmacytechnician #aseptictechnique #gowning #hospitalpharmacy


Sharpen your aseptic technique skills! Aseptic technique is crucial for preventing contamination in sterile compounding. Want to know more? Check out our explanation on Facebook! facebook.com/qualifiedhub/ #SterileCompounding #AsepticTechnique #PharmTech #Nurse #AskUsAnything

Here is my price list for all treatments i provide. #safetyfirst #medicalaestheticpractitioner #Aseptictechnique #claireabellaaesthetics

خطوة واحدة خاطئة في الgowningممكن تسبب فشل الميديا فيل وتلوث كامل للمنطقة العقيمة! 📽️ في هذا الفيديو أوضح طريقة لبس بدلة المنطقة العقيمة خطوة بخطوة 🎯 تابع الفيديو على قناتي من هنا: [youtu.be/CNGhAO2-Gb0?si…] #Gowning #SterileArea #AsepticTechnique #Pharmaceutical #Cleanroom
![Zezo01227270474's tweet image. خطوة واحدة خاطئة في الgowningممكن تسبب فشل الميديا فيل وتلوث كامل للمنطقة العقيمة! 📽️ في هذا الفيديو أوضح طريقة لبس بدلة المنطقة العقيمة خطوة بخطوة
🎯 تابع الفيديو على قناتي من هنا: [youtu.be/CNGhAO2-Gb0?si…]
#Gowning #SterileArea #AsepticTechnique #Pharmaceutical #Cleanroom](https://pbs.twimg.com/media/GvrTVg-XIAEt-bR.jpg)
Aseptic technique is vital in nursing, with varied applications. This review of 2812 studies and 31 articles reveals differences in terminology around aseptic technique. This will guide future research #Nursing #AsepticTechnique #Research journalofhospitalinfection.com/article/S0195-…
journalofhospitalinfection.com
Aseptic technique in clinical nursing settings: a scoping review
Aseptic technique forms a component of standard precautions and is a foundational concept in nursing practice. The application of that standard appears to vary between context and nurse. The variat...
#AsepticTechnique 🦠 🧼 ✋ 🤚 #mroshieldsscience #Science #WashYourHands #LabSkills #AvoidContamination #chemistry #mroshieldschemistry #handwashing
خطوة واحدة خاطئة في الgowningممكن تسبب فشل الميديا فيل وتلوث كامل للمنطقة العقيمة! 📽️ في هذا الفيديو أوضح طريقة لبس بدلة المنطقة العقيمة خطوة بخطوة 🎯 تابع الفيديو على قناتي من هنا: [youtu.be/CNGhAO2-Gb0?si…] #Gowning #SterileArea #AsepticTechnique #Pharmaceutical #Cleanroom
![Zezo01227270474's tweet image. خطوة واحدة خاطئة في الgowningممكن تسبب فشل الميديا فيل وتلوث كامل للمنطقة العقيمة! 📽️ في هذا الفيديو أوضح طريقة لبس بدلة المنطقة العقيمة خطوة بخطوة
🎯 تابع الفيديو على قناتي من هنا: [youtu.be/CNGhAO2-Gb0?si…]
#Gowning #SterileArea #AsepticTechnique #Pharmaceutical #Cleanroom](https://pbs.twimg.com/media/GvrTVg-XIAEt-bR.jpg)
Automated Aseptic Technique: Revolutionizing Infection Control in Healthcare #AsepticTechnique #InfectionControl #HealthcareAutomation #MedicalTechnology #CleanTouchpoint #SurgicalInnovation #PatientSafety #HealthcareEfficiency #MedicalInnovation #FutureOfHealthcare
6.Penggunaan Laminar Air Flow "Laminar air flow = alat wajib untuk kerja aseptik! Menghasilkan aliran udara steril yang melindungi sampel dari kontaminasi. Kunci untuk hasil pangan yang higienis dan aman. #LaminarFlow #AsepticTechnique" @gadjah872911712
2. "Going aseptic! When working with microorganisms, it's essential to follow proper aseptic technique to prevent contamination and ensure reliable results. Remember to sterilize equipment wear protective gear, and work in a controlled environment #AsepticTechnique #microbiology
1. "Aseptik technique is crucial in laboratory settings to prevent contamination and ensure accurate results! Always wear gloves, use sterile equipment, and work in a laminar flow hood to minimize risks. #AsepticTechnique #LaboratorySafety"
Tweet 2: "Why is sterilization of equipment and work environment important in food production? Because with good aseptic technique, we can produce safe and high-quality food products. Let's work together to maintain food safety and hygiene! #AsepticTechnique #FoodSafety"
Twit 1 Aseptic technique is crucial in food processing to prevent contamination and ensure food safety. Let's prioritize cleanliness and sterility in every step of food production! #AsepticTechnique #FoodSafety
🧑⚕️💊 Aseptic Gowning in Action! Pharmacy technician students are mastering aseptic technique, ensuring contamination-free medication prep. From gloves to gowns, every step matters for patient safety! 🏥✨ #pharmacytechnician #aseptictechnique #gowning #hospitalpharmacy


The wait is almost over! Get ready to be inspired! Stay tuned! News and testimonials are coming soon. #sterilecompounding #aseptictechnique #pharmacy #training #successstories #nextround #qualified_hub #qualified_pharmacists_hub #pharmacist

Want to stay ahead of the curve and gain in-depth knowledge? Enroll now qualified.ws/sterile-compou… #sterilecompounding #aseptictechnique #pharmacy #training #qa #healthcare #qualitips #qualified_hub #qualified_pharmacists_hub #ChemoMyths #pharmacist #SterileCompounding

Sharpen your aseptic technique skills! Aseptic technique is crucial for preventing contamination in sterile compounding. Want to know more? Check out our explanation on Facebook! facebook.com/qualifiedhub/ #SterileCompounding #AsepticTechnique #PharmTech #Nurse #AskUsAnything

Doctors, can you ace this sterile compounding quiz? Show off your aseptic technique knowledge! Take it now & see if you're an expert! #sterilecompounding #aseptictechnique #MayTraining

Great poster by @ValWeston6 @fionahammond74 on achieving informal #consensus on #aseptictechnique for shared #learning and understanding @teamCNO_ @Lisaritchie111 @samalexmatthews #IP2023Conf

Alam kong mahirap sa simula pero kailangan mo kumawala kung nasan kaman. Matuto sa mga pagkakamali, buksan ang pag-iisip, at mag-mahal muli sa tamang oras at panahon. ❤️ #sidedrip #startnewline #aseptictechnique #nursehokage

Having a brilliant day facilitating wound care #simulation with our amazing September 2022 adult nursing students!! @ShuAdultNursing @sheffhallamuni #learningisfun #aseptictechnique #notouchtechnique

Great 1st session of our Sterile Compounding & Aseptic Technique Training! Participants loved it & are eager to learn more. #pharmacytraining #sterilecompounding #aseptictechnique




Test your knowledge! What is the definition of aseptic technique?? A) B) C) D) Vote & share your best #aseptictechnique tip in the replies! #infectionprevention #patientcare

IV compounding challenge: Can you spot the TINY mistake that could lead to a BIG problem? Drop your answer in the comments & see if you're a sterile compounding master!🥼 #qualifiedhub #sterilecompounding #aseptictechnique #pharmacy

The wait is almost over! Get ready to be inspired! Stay tuned! News and testimonials are coming soon. #sterilecompounding #aseptictechnique #pharmacy #training #successstories #nextround #qualified_hub #qualified_pharmacists_hub #pharmacist

What do you think presents the biggest challenge in implementing the recommended sterile compounding techniques and guidelines? Leave a comment below with your guess! #sterilecompounding #aseptictechnique #pharmacy

Do you know of a major infection outbreak that played a role in the development of sterile compounding practices? Share your knowledge or best guesses in the comments below! #qualifiedhub #sterilecompounding #aseptictechnique #pharmacy

Doctors, can you ace this sterile compounding quiz? Show off your aseptic technique knowledge! Take it now & see if you're an expert! #sterilecompounding #aseptictechnique #MayTraining

Here is my price list for all treatments i provide. #safetyfirst #medicalaestheticpractitioner #Aseptictechnique #claireabellaaesthetics

S3 Biology have been learning about antibiotics and the use of them for bacterial infections. Here are the before and after pics of their plates. Of course, we needed to learn about Sir Alexander Fleming along the way too!🏴 #LearningTogether #AsepticTechnique

Want to stay ahead of the curve and gain in-depth knowledge? Enroll now qualified.ws/sterile-compou… #sterilecompounding #aseptictechnique #pharmacy #training #qa #healthcare #qualitips #qualified_hub #qualified_pharmacists_hub #ChemoMyths #pharmacist #SterileCompounding

Thank you @Corning @VWR for an in-person #laboratory demonstration on #tissueculture and #aseptictechnique for new lab members. @WeillCornell #CancerResearch



Sharpen your aseptic technique skills! Aseptic technique is crucial for preventing contamination in sterile compounding. Want to know more? Check out our explanation on Facebook! facebook.com/qualifiedhub/ #SterileCompounding #AsepticTechnique #PharmTech #Nurse #AskUsAnything

🧑⚕️💊 Aseptic Gowning in Action! Pharmacy technician students are mastering aseptic technique, ensuring contamination-free medication prep. From gloves to gowns, every step matters for patient safety! 🏥✨ #pharmacytechnician #aseptictechnique #gowning #hospitalpharmacy


One week later from the index case (my 7 year old), I am the last one standing from the 6 in our home. I am not going down with norovirus (stomach flu) without a fight. Armed with bleach and lots of hand washing! #VirologyProf #FightingHard #AsepticTechnique

خطوة واحدة خاطئة في الgowningممكن تسبب فشل الميديا فيل وتلوث كامل للمنطقة العقيمة! 📽️ في هذا الفيديو أوضح طريقة لبس بدلة المنطقة العقيمة خطوة بخطوة 🎯 تابع الفيديو على قناتي من هنا: [youtu.be/CNGhAO2-Gb0?si…] #Gowning #SterileArea #AsepticTechnique #Pharmaceutical #Cleanroom
![Zezo01227270474's tweet image. خطوة واحدة خاطئة في الgowningممكن تسبب فشل الميديا فيل وتلوث كامل للمنطقة العقيمة! 📽️ في هذا الفيديو أوضح طريقة لبس بدلة المنطقة العقيمة خطوة بخطوة
🎯 تابع الفيديو على قناتي من هنا: [youtu.be/CNGhAO2-Gb0?si…]
#Gowning #SterileArea #AsepticTechnique #Pharmaceutical #Cleanroom](https://pbs.twimg.com/media/GvrTVg-XIAEt-bR.jpg)
a"��Tip: For successful plant tissue culture, maintain aseptic conditions. Use a laminar flow hood for sterilizing media & tools. #PlantTissueCulture #Micropropagation ���� #AsepticTechnique #LabTips"

Something went wrong.
Something went wrong.
United States Trends
- 1. Cheney 71.3K posts
- 2. Sedition 136K posts
- 3. Treason 81.4K posts
- 4. First Take 44.8K posts
- 5. Mark Walter 1,077 posts
- 6. Jeanie 1,409 posts
- 7. Cam Newton 3,752 posts
- 8. Seditious 71.6K posts
- 9. Trump and Vance 34.8K posts
- 10. Commander in Chief 44.3K posts
- 11. #WeekndTourLeaks 1,443 posts
- 12. Constitution 100K posts
- 13. Coast Guard 16.7K posts
- 14. Shayy 11.4K posts
- 15. Nano Banana Pro 21.2K posts
- 16. #ExpediaChat 1,177 posts
- 17. Dameon Pierce N/A
- 18. #Geeksgiving25 N/A
- 19. Congratulations Bill N/A
- 20. Stephen A 40.9K posts


















